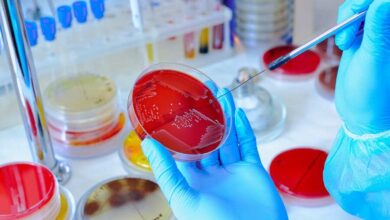

Ocurrirán nuevas pandemias, advierten los expertos
mayo 19, 2020
Notimex. Ante la falta de un cambio de comportamiento grave e inmediato, “es probable que ocurran pandemias con más frecuencia, se propaguen más rápidamente, tengan un mayor impacto económico y maten a más personas”, advierte la Plataforma Intergubernamental de Ciencia y Política sobre Servicios de Biodiversidad y Ecosistemas (IPBES por sus siglas en inglés).
La COVID-19 ha demostrado la interdependencia de los humanos y el medio ambiente. Al representar sólo una de las ocho millones de especies estimadas en el planeta, somos una pequeña parte de una intrincada red de vida delicadamente equilibrada, por lo que el daño a una parte altera el equilibrio y afecta a todo el sistema.
Sin embargo, indica que la pandemia también representa una oportunidad para planificar una mejor recuperación y construir un futuro mejor, por lo que la Organización de las Naciones Unidas (ONU) apoyará a todos los gobiernos para que sigan la Agenda 2030 para el Desarrollo Sostenible, los Objetivos de Desarrollo Sostenible y el Acuerdo de París sobre el cambio climático, para garantizar que las personas emerjan más fuertes.
Al reconocer la naturaleza como una solución a algunos de los desafíos más apremiantes de la humanidad, el Programa de las Naciones Unidas para el Medio Ambiente (PNUMA) y sus socios han lanzado el Decenio de las Naciones Unidas sobre la Restauración del Ecosistema 2021-2030.
Con él, se busca prevenir, detener e invertir la degradación de los ecosistemas en todo el mundo, por lo que el PNUMA también trabaja con los líderes mundiales para desarrollar un nuevo y ambicioso Marco Global de Biodiversidad Post-2020.
El 5 de junio, Día Mundial del Medio Ambiente, la agencia de la ONU buscará involucrar a los gobiernos, empresas, celebridades y ciudadanos a replantear su relación con la naturaleza y llamará a los líderes a tomar decisiones que pongan a la naturaleza en el centro.